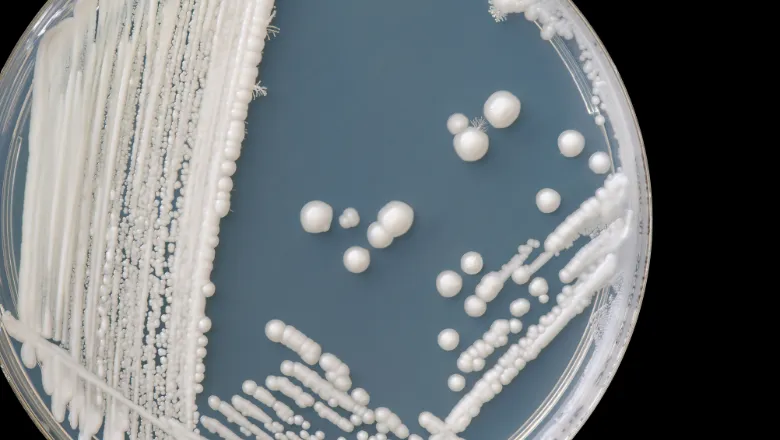

New cancer drug boosts effectiveness of chemotherapy – even in resistant tumours
A groundbreaking cancer drug could enhance how patients respond to chemotherapy even in treatment-resistant tumours….
Antifungal discovery offers hope against deadly drug-resistant infections
Scientists at King’s have developed a new class of antifungal compounds that could offer a…
Global action urgently needed to tackle antimicrobial resistance, experts warn
Researchers from King’s College London have called for urgent changes to the way new antibiotics…
Grant supports effective antibiotics for people with cystic fibrosis
King’s and the UK Health Security Agency (UKHSA) have been awarded a joint grant to…
King’s biotech spinout Pheon Therapeutics Raises $120m to develop novel anticancer agents
The investment raised at the close of its Series B funding round will enable Pheon…
King’s biotech spinout re-launches with new name and $68 million funding
Pheon Therapeutics, which has its origins in research carried out in the Institute of Pharmaceutical…